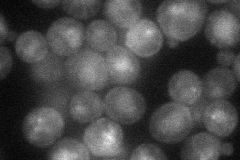
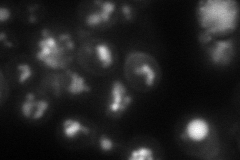
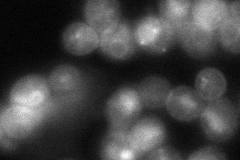
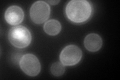

View description
Myo-inositol transporter with strong similarity to the minor myo-inositol transporter Itr2p, member of the sugar transporter superfamily; expression is repressed by inositol and choline via Opi1p and derepressed via Ino2p and Ino4p
Localization:
Intensity:
Fold change:
Significance:
-
C’ GFP library in SD

cell periphery178.56 -
N' NOP1pr-GFP in SD
cell periphery,vacuole45.929 -
N' TEF2pr-mCherry in SD
cell periphery,vacuole59.5194 -
N' NATIVEpr-GFP in SD
cell periphery,ER,vacuole97.8147 -
N' TEF2pr-VC and Cyto-VN in SD

below threshold25.9965 -
C’ GFP library in SD+DTT
cell periphery115.050.64No -
C’ GFP library in SD+H2O2

punctateN/AN/ANo -
C’ GFP library in Starvation Media

vacuoleN/AN/AYes -
C’ GFP library on the background of Pup2-DaMP

cell periphery -
C’ GFP library on the background of CCT mutant

cell periphery122.2960.68488Yes
